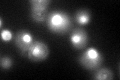
YMR014W
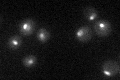
YMR014W

View description
Protein involved in bud-site selection; diploid mutants display a random budding pattern instead of the wild-type bipolar pattern
Localization:
Intensity:
Fold change:
Significance:
-
C’ GFP library in SD

nucleolus51.37 -
N' NOP1pr-GFP in SD

nucleolus82.7656 -
N' TEF2pr-mCherry in SD

nucleus,nucleolus107.075 -
N' NATIVEpr-GFP in SD

nucleolus42.2971 -
N' TEF2pr-VC and Cyto-VN in SD

#N/A0 -
C’ GFP library in SD+DTT
nucleolus43.080.83No -
C’ GFP library in SD+H2O2

nucleolus48.630.94No -
C’ GFP library in Starvation Media
nucleolus27.590.53Yes -
C’ GFP library on the background of Pup2-DaMP

nucleolus -
C’ GFP library on the background of CCT mutant

nucleolus46.05850.896382No
